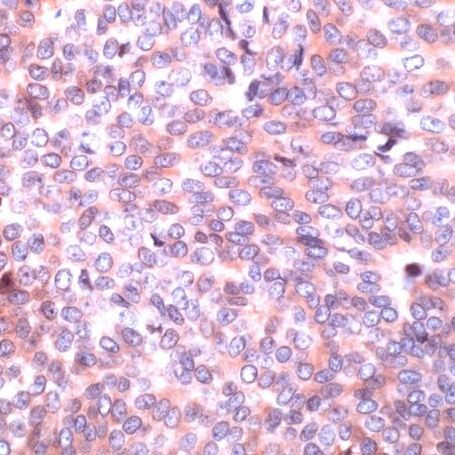
PAK2 Antibody in Immunohistochemistry (IHC)

Search
Invitrogen
PAK2 Polyclonal Antibody
{{$productOrderCtrl.translations['antibody.pdp.commerceCard.promotion.promotions']}}
{{$productOrderCtrl.translations['antibody.pdp.commerceCard.promotion.viewpromo']}}
{{$productOrderCtrl.translations['antibody.pdp.commerceCard.promotion.promocode']}}: {{promo.promoCode}} {{promo.promoTitle}} {{promo.promoDescription}}. {{$productOrderCtrl.translations['antibody.pdp.commerceCard.promotion.learnmore']}}
产品信息
PA5-32536
宿主/亚型
分类
类型
抗原
偶联物
形式
浓度
保存条件
运输条件
RRID
产品详细信息
This antibody is predicted to react with bovine and mouse based on sequence homology.
Heat-mediated antigen retrieval is recommended prior to staining, using a 10mM citrate buffer, pH 6.0, for 10 minutes followed by cooling at room temperature for 20 min. Following antigen retrieval, incubate samples with primary antibody for 30 min at room temperature. A suggested positive control is breast carcinoma.
靶标信息
PAK2 (serine/threonine-protein kinase PAK2) is a serine/threonine kinase that plays a role in a variety of different signaling pathways including cytoskeleton regulation, cell motility, cell cycle progression, apoptosis, or proliferation. It acts as a downstream effector of the small GTPases CDC42 and RAC1. Activation by the binding of active CDC42 and RAC1 results in a conformation change and a subsequent autophosphorylation on several serine and/or threonine residues. Full-length PAK2 stimulates cell survival and cell growth. PAK proteins are critical effectors that link Rho GTPases to cytoskeleton reorganization and nuclear signaling. PAK proteins, a family of serine/threonine p21-activating kinases, serve as targets for the small GTP binding proteins Cdc42 and RAC and have been implicated in a wide range of biological activities.
仅用于科研。不用于诊断过程。未经明确授权不得转售。